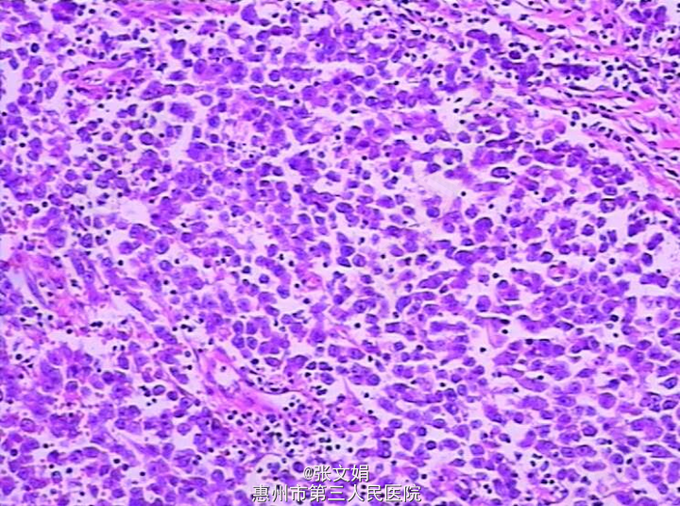

下载或打开 医联APP 查看完整评论
立即下载
打开APP
左侧睾丸精原细胞瘤一例
主诉 病史
主诉:发现左侧阴囊肿大1月余 病史:患者无意中发现左侧阴囊肿大,无伴疼痛,发热,无腹痛腹胀,到我院门诊行CT检查,考虑左侧睾丸恶性肿瘤可能性大。
查体 辅查
查体:左侧阴囊肿大,无疼痛。大小约为3cm*2cm大,类圆形,边缘稍规整。其余无特殊。 辅查:门诊CT检查,考虑左侧睾丸恶性肿瘤可能性大。 PET示:左侧睾丸恶性肿瘤(生殖细胞瘤)可能性,右侧斜裂小结节,考虑肉芽肿。 术后病理提示:(左侧睾丸)精原细胞瘤。

诊断 处理
诊断:左侧睾丸精原细胞瘤 处理:行左侧睾丸根治性切除术
随访 讨论
随访:依托泊苷针、奈达铂针 、博莱霉素针(进)化疗4程,复查CT后,未发现转移和复发。 讨论:任何睾丸肿瘤应先行高位睾丸摘除术,然后根据病理类型和临床分期选择治疗方案。精原细胞高度放射敏感,较低剂量就能消灭转移病灶而不产生明显的放射损伤。
发布于 15-07-13 17:12
共 0 个评论
暂无评论
